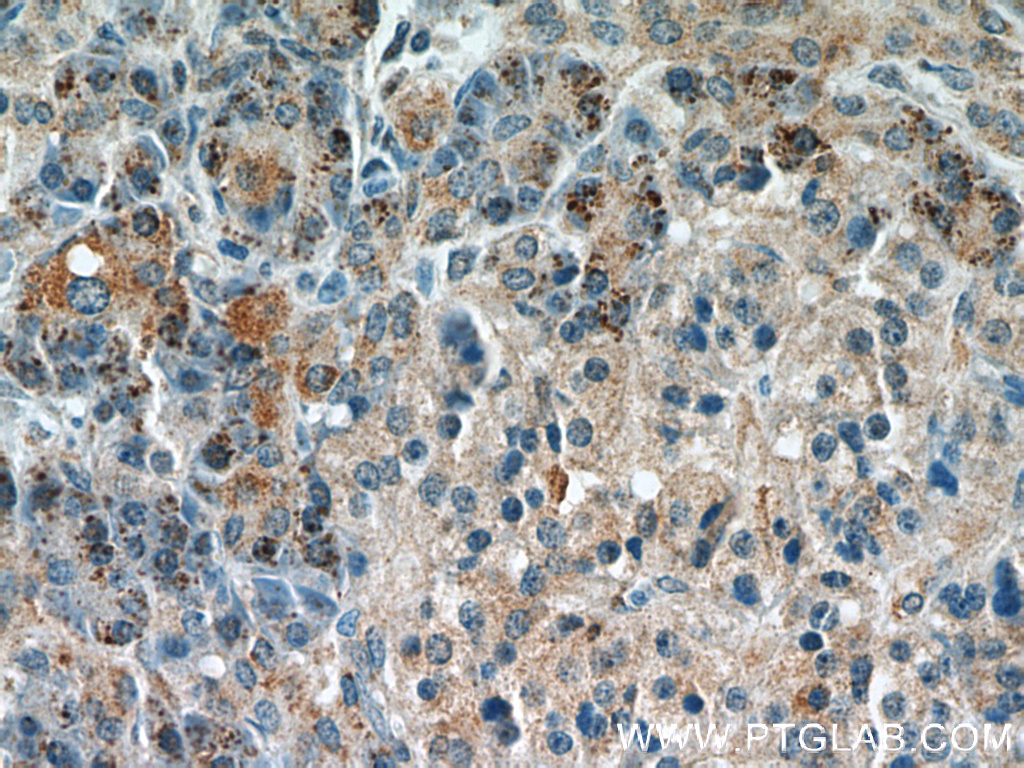

验证数据展示
经过测试的应用
| Positive WB detected in | HEK-293 cells, BxPC-3 cells, human brain tissue, human heart tissue, mouse heart tissue, mouse brain tissue, mouse kidney tissue |
| Positive IHC detected in | human lung cancer tissue, human kidney tissue, mouse brain tissue, human pancreas tissue Note: suggested antigen retrieval with TE buffer pH 9.0; (*) Alternatively, antigen retrieval may be performed with citrate buffer pH 6.0 |
| Positive IF/ICC detected in | HepG2 cells |
推荐稀释比
| 应用 | 推荐稀释比 |
|---|---|
| Western Blot (WB) | WB : 1:1000-1:6000 |
| Immunohistochemistry (IHC) | IHC : 1:50-1:500 |
| Immunofluorescence (IF)/ICC | IF/ICC : 1:20-1:200 |
| It is recommended that this reagent should be titrated in each testing system to obtain optimal results. | |
| Sample-dependent, Check data in validation data gallery. | |
产品信息
14259-1-AP targets Syntaxin 12 in WB, IHC, IF/ICC, IP, ELISA applications and shows reactivity with human, mouse, rat samples.
| 经测试应用 | WB, IHC, IF/ICC, ELISA Application Description |
| 文献引用应用 | WB, IF, IP |
| 经测试反应性 | human, mouse, rat |
| 文献引用反应性 | human, rat |
| 免疫原 |
CatNo: Ag5532 Product name: Recombinant human STX12 protein Source: e coli.-derived, PGEX-4T Tag: GST Domain: 1-254 aa of BC046999 Sequence: MSYGPLDMYRNPGPSGPQLRDFSSIIQTCSGNIQRISQATAQIKNLMSQLGTKQDSSKLQENLQQLQHSTNQLAKETNELLKELGSLPLPLSTSEQRQQRLQKERLMNDFSAALNNFQAVQRRVSEKEKESIARARAGSRLSAEERQREEQLVSFDSHEEWNQMQSQEDEVAITEQDLELIKERETAIRQLEADILDVNQIFKDLAMMIHDQGDLIDSIEANVESSEVHVERATEQLQRAAYYQKKSRKKMCIL 种属同源性预测 |
| 宿主/亚型 | Rabbit / IgG |
| 抗体类别 | Polyclonal |
| 产品类型 | Antibody |
| 全称 | syntaxin 12 |
| 别名 | STX12, Syntaxin-12 |
| 计算分子量 | 32 kDa |
| 观测分子量 | 33-39 kDa, 66 kDa |
| GenBank蛋白编号 | BC046999 |
| 基因名称 | Syntaxin 12 |
| Gene ID (NCBI) | 23673 |
| RRID | AB_2198222 |
| 偶联类型 | Unconjugated |
| 形式 | Liquid |
| 纯化方式 | Antigen affinity purification |
| UNIPROT ID | Q86Y82 |
| 储存缓冲液 | PBS with 0.02% sodium azide and 50% glycerol, pH 7.3. |
| 储存条件 | Store at -20°C. Stable for one year after shipment. Aliquoting is unnecessary for -20oC storage. |
背景介绍
Syntaxin 12 (STX12), also known as STX13 or STX14, is a 276 amino acid single-pass type IV membrane protein that belongs to the syntaxin family. It is a broadly and differentially expressed SNARE protein, highly enriched in brain tissue. STX12 is localized to early and recycling endosomes and is involved in the recycling of plasma membrane proteins. It also has a role in the trafficking of MMP during the degradation of ECM substrates and subsequent cellular invasion. (PMID: 9507000; 9553086; 19910495) This antibody recognizes a major 39 kDa band of endogenous STX12. In some cases, two additional bands of 33 kDa and 66 kDa could also be detected, which most likely represent a degradation product and a SNARE complex respectively (PMID: 9817754).
实验方案
| Product Specific Protocols | |
|---|---|
| IF protocol for Syntaxin 12 antibody 14259-1-AP | Download protocol |
| IHC protocol for Syntaxin 12 antibody 14259-1-AP | Download protocol |
| WB protocol for Syntaxin 12 antibody 14259-1-AP | Download protocol |
| Standard Protocols | |
|---|---|
| Click here to view our Standard Protocols |
发表文章
| Species | Application | Title |
|---|---|---|
Mol Cell Syntaxin 13, a Genetic Modifier of Mutant CHMP2B in Frontotemporal Dementia, Is Required for Autophagosome Maturation.
| ||
PLoS Biol Nucleotide de novo synthesis increases breast cancer stemness and metastasis via cGMP-PKG-MAPK signaling pathway. | ||
Biochem J Phosphoproteomics reveals that the hVPS34 regulated SGK3 kinase specifically phosphorylates endosomal proteins including Syntaxin-7, Syntaxin-12, RFIP4 and WDR44. | ||
J Biol Chem Competition for cysteine acylation by C16:0 and C18:0 derived lipids is a global phenomenon in the proteome | ||
Mol Biol Cell Rab11 regulates autophagy at dendritic spines in an mTOR- and NMDA-dependent manner |